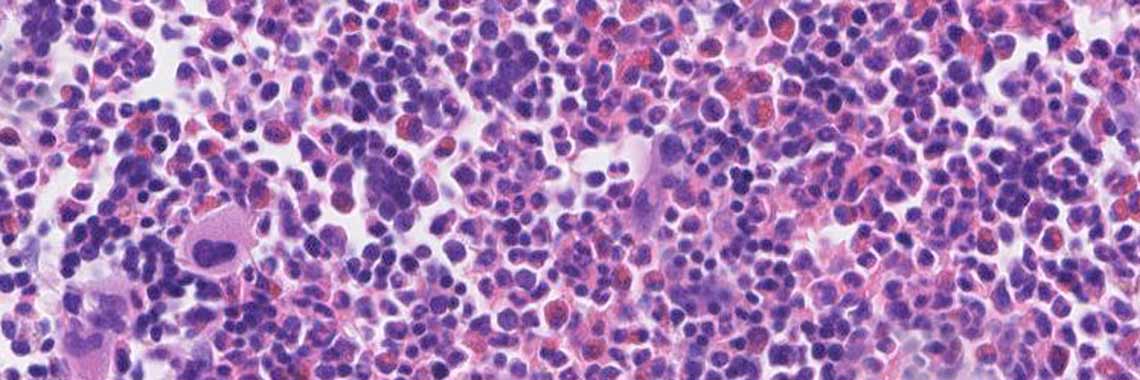

Veranstaltungen/Workshops
Der Nora-Verlag bietet nun schon seit vielen Jahren interaktive und praxisnahe Fortbildungsveranstaltungen im Bereich der Hämatologie und der internistischen Onkologie an.
Hämatologische Mikroskopierkurse
Hämatologische Mikroskopierkurse:
Praxisnahe Fortbildungen in der mikroskopischen Diagnostik hämatologischer Erkrankungen